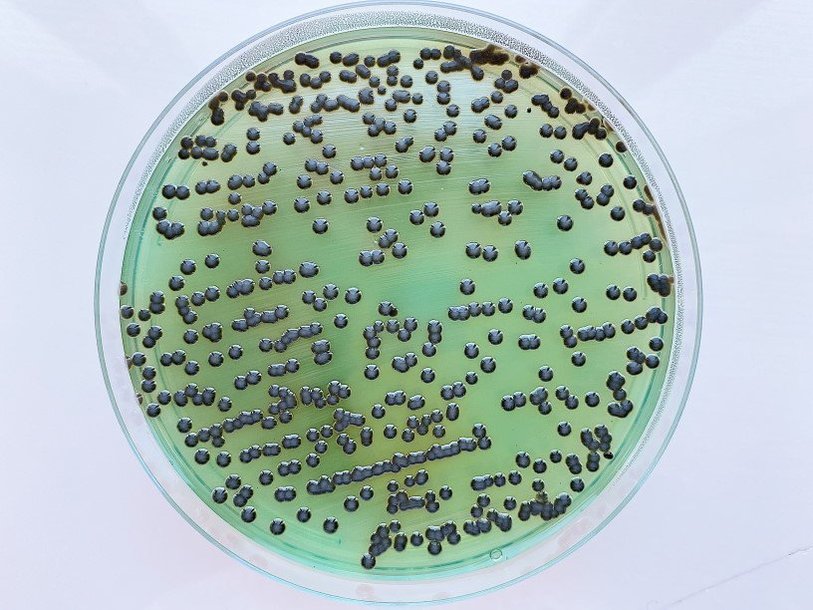

Екатерина Беленко: Промикробы: Коррозия металла
Висмут-сульфит агар Фото: Екатерина Беленко
Висмут-сульфит агар Фото: Екатерина Беленко Сегодня я познакомлю вас с новой питательной средой, она называется «висмут-сульфит агар». Про то, что такое агар, я думаю все уже запомнили: это плотные питательные среды с добавлением агар-агара. А зачем в эту среду добавили висмут и что из этого получилось? И вообще, что это за висмут такой?
⠀
Висмут — химический элемент номер 83. Простое вещество представляет собой при нормальных условиях блестящий, серебристый, с розоватым оттенком металл. Он известен ещё со Средневековья, вовсю использовался алхимиками. Висмут содержится в земной коре, в морской воде и даже — в каких-то ничтожных количествах — в теле человека. Висмут — достаточно редкий металл, и его мировая добыча составляет около 6000 тонн в год. Цена на металлический висмут существенно зависит от его чистоты. Средневзвешенная цена на мировом рынке на конец 2016 г. составляла около 10 $/кг.
Висмут-сульфит агар — это питательная среда, предназначенная для выделения сальмонелл. Все хоть раз слышали о сальмонеллах, я уверена. Это целый род грамотрицательных палочек, некоторые виды этого рода являются возбудителями брюшного тифа, паратифов и других сальмонеллезов. Они неприхотливы и растут на простых питательных средах, но висмут-сульфит агар позволяет не просто вырастить, а сразу «узнать» сальмонеллу. Бриллиантовый зеленый и висмут, который находится в среде в виде основного сульфита, подавляют рост грамположительной флоры и многих энтеробактерий, в том числе шигелл. То есть на этой среде не каждая бактерия может жить и процветать, что очень удобно для нас.
⠀
Получается, большую часть микробов мы уже отсеяли — они тупо не могут вырасти. Но надо из оставшихся, которые всё же могут расти, еще как-то отделить именно сальмонелл. Дифференцирующее действие среды основано на том, что образуемый бактериями из сульфата железа сероводород вызывает почернение индикатора — бесцветного сульфита висмута — вследствие перехода его в сульфид висмута, вещество черного цвета. Поэтому бактерии, образующие сероводород, формируют совсем черные или черные с коричневым или темно-зеленым оттенком колонии, обладающие часто металлическим блеском. Среда под колониями при этом окрашена в черный цвет. Бактерии, не образующие сероводород, могут вырастать в виде мелких бесцветных, зеленых и коричневых колоний, но без потемнения среды.
⠀
А еще эта среда очень удобна с практической точки зрения — она требует гораздо меньше мер предосторожности по стерильности. Даже если при приготовлении, розливе или хранении на нее попадет залетный микроб, его будущее незавидно. В официальных описаниях питательных сред есть графа «цвет», мне очень нравится, как определен там цвет этой среды — зеленовато-гороховый. Гороховый супчик с тяжелым металлом.